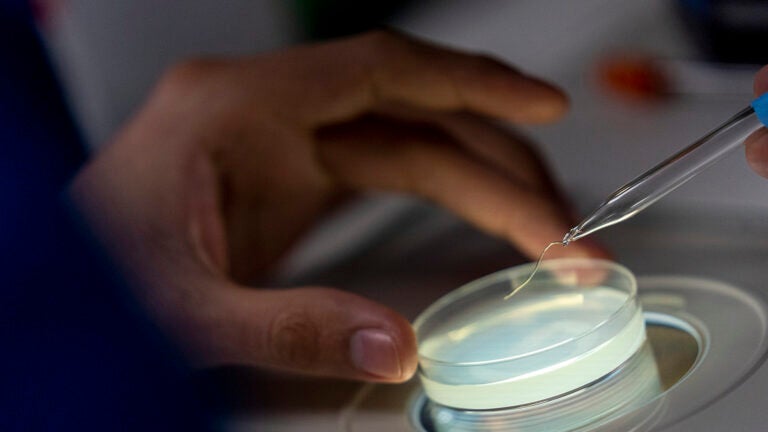
Hand holding clear dish

Research & Innovation
Research is what we do best because we’ve created a dynamic, collaborative ecosystem to produce timely, quality work. Breaking silos is what we do. Students at all levels are encouraged to participate in cross-disciplinary research projects, working with distinguished faculty and our surrounding community. Industries around the world look to USC for leadership, inspiration and opportunities to partner around today’s most important and immediate questions.
Tackling Today’s Problems, Saving Lives Through Research
From health innovations to community transformation, USC’s research delivers tangible breakthroughs that make a difference.
Can Diabetes Drugs Help Fight Alzheimer’s?
USC, UCLA team up for the world’s first-in-human bladder transplant
The Paralyzed Will Walk, the Blind Will See: The Bionics Revolution Is Coming

Research That Saves Lives
USC is one of the nation’s premier research institutions, where bold ideas and cross-disciplinary collaboration fuel discovery and innovation. Our researchers tackle society’s most urgent challenges, delivering solutions that save lives and improve communities around the world.
Student Research
Students are integrated in every level of the research that happens at USC. Learn how students contribute to important advances.

Faculty Research
Our top-notch faculty make us one of the leading private research universities in the country. Find out what they’re working on.

Research Resources
Our resources empower USC’s research community to be creative, make astonishing discoveries and translate findings for the betterment of humanity. Find support, methods and tools to make these endeavors happen.

A Place for Innovation
Thinkers and doers thrive in USC’s collaborative, multidisciplinary environment. We foster an entrepreneurial culture focused on solving problems to improve the human condition — and it all starts with innovation.

Centers & Institutes
Spanning a wide array of disciplines and specialties, USC’s centers and institutes are the hotbeds of innovative inquiry and collaboration pushing the frontiers of knowledge forward. USC’s interdisciplinary research ecosystem includes numerous cross-school research projects, programs and initiatives.
Research News
The collaborative group of doctoral students and faculty is producing accessible policy research and engaging with policymakers who are shaping the future of K-12 and higher education.
USC researchers find willingness to travel for health care varies by income, mobility and location — insights that could impact the growth of telehealth as well as transportation planning.
Cutting-edge technologies developed by USC researchers are changing not just the pace of Alzheimer’s disease discoveries but also the ways scientists make those discoveries.
Drinking patterns — not just total drinks — may cause harm even in moderate drinkers, a new USC study suggests.

USC Recognized as a Leading Research University
The University of Southern California (USC) is one of the nation’s leading private research universities, recognized for its breadth of discovery and innovation across disciplines including engineering, health sciences, computing, and the social sciences. USC manages more than $1 billion annually in research expenditures, placing it among a select group of private universities with research activity exceeding that threshold. Federal agencies such as the National Institutes of Health, Department of Defense, and National Science Foundation are major sponsors of USC research.
The university is classified by the Carnegie Foundation as an R1: Doctoral University with Very High Research Activity, reflecting its substantial research funding and robust production of doctoral degrees.










